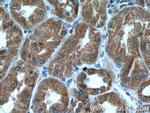
ZC3HAV1 Antibody in Immunohistochemistry (Paraffin) (IHC (P))

Search
Proteintech
ZC3HAV1 Monoclonal Antibody (1G10B9)
{{$productOrderCtrl.translations['antibody.pdp.commerceCard.promotion.promotions']}}
{{$productOrderCtrl.translations['antibody.pdp.commerceCard.promotion.viewpromo']}}
{{$productOrderCtrl.translations['antibody.pdp.commerceCard.promotion.promocode']}}: {{promo.promoCode}} {{promo.promoTitle}} {{promo.promoDescription}}. {{$productOrderCtrl.translations['antibody.pdp.commerceCard.promotion.learnmore']}}
产品信息
66413-1-IG
种属反应
宿主/亚型
分类
类型
克隆号
抗原
偶联物
形式
浓度
规格
纯化类型
保存液
内含物
保存条件
运输条件
产品详细信息
Immunogen sequence: MADPEVCCF ITKILCAHGG RMALDALLQE IALSEPQLCE VLQVAGPDRF VVLETGGEAG ITRSVVATTR ARVCRRKYCQ RPCDNLHLCK LNLLGRCNYS QSERNLCKYS HEVLSEENFK VLKNHELSGL NKEELAVLLL QSDPFFMPEI CKSYKGEGRQ QICNQQPPCS RLHICDHFTR GNCRFPNCLR SHNLMDRKVL AIMREHGLNP DVVQNIQDIC NSKHMQKNPP GPRAPSSHRR NMAYRARSKS RDRFFQGSQE FLASASASAE RSCTPSPDQI SHRASLEDAP VDDLTRKFTY LGSQDRARPP SGSSKATDLG GTSQAGTSQR FLENGSQEDL LHGNPGSTYL AS (1-351 aa encoded by BC025308)
靶标信息
The zinc finger antiviral protein (ZC3HAV1) is a CCCH type zinc finger protein that induces an innate immunity to infections by retrovirus by preventing the accumulation of viral RNAs in the cytoplasm and recruits the RNA processing exosome to degrade target RNAs, thereby inhibiting virus replication. ZC3HAV1 is localized in the cytoplasm at steady state, but shuttles between nucleus and cytoplasm in a XPO1-dependent manner. ZAP is a direct target gene of IRF3 action in cellular antiviral responses.
仅用于科研。不用于诊断过程。未经明确授权不得转售。
生物信息学
蛋白别名: ADP-ribosyltransferase diphtheria toxin-like 13; ARTD13; Inactive Poly [ADP-ribose] polymerase 13; PARP13; predicted protein of HQ1677; unnamed protein product; ZAP; Zinc finger antiviral protein; Zinc finger CCCH domain-containing protein 2; Zinc finger CCCH-type antiviral protein 1; zinc finger CCCH-type, antiviral 1
基因别名: ARTD13; FLB6421; PARP13; PRO1677; ZAP; ZC3H2; ZC3HAV1; ZC3HDC2
UniProt ID: (Human) Q7Z2W4
Entrez Gene ID: (Human) 56829